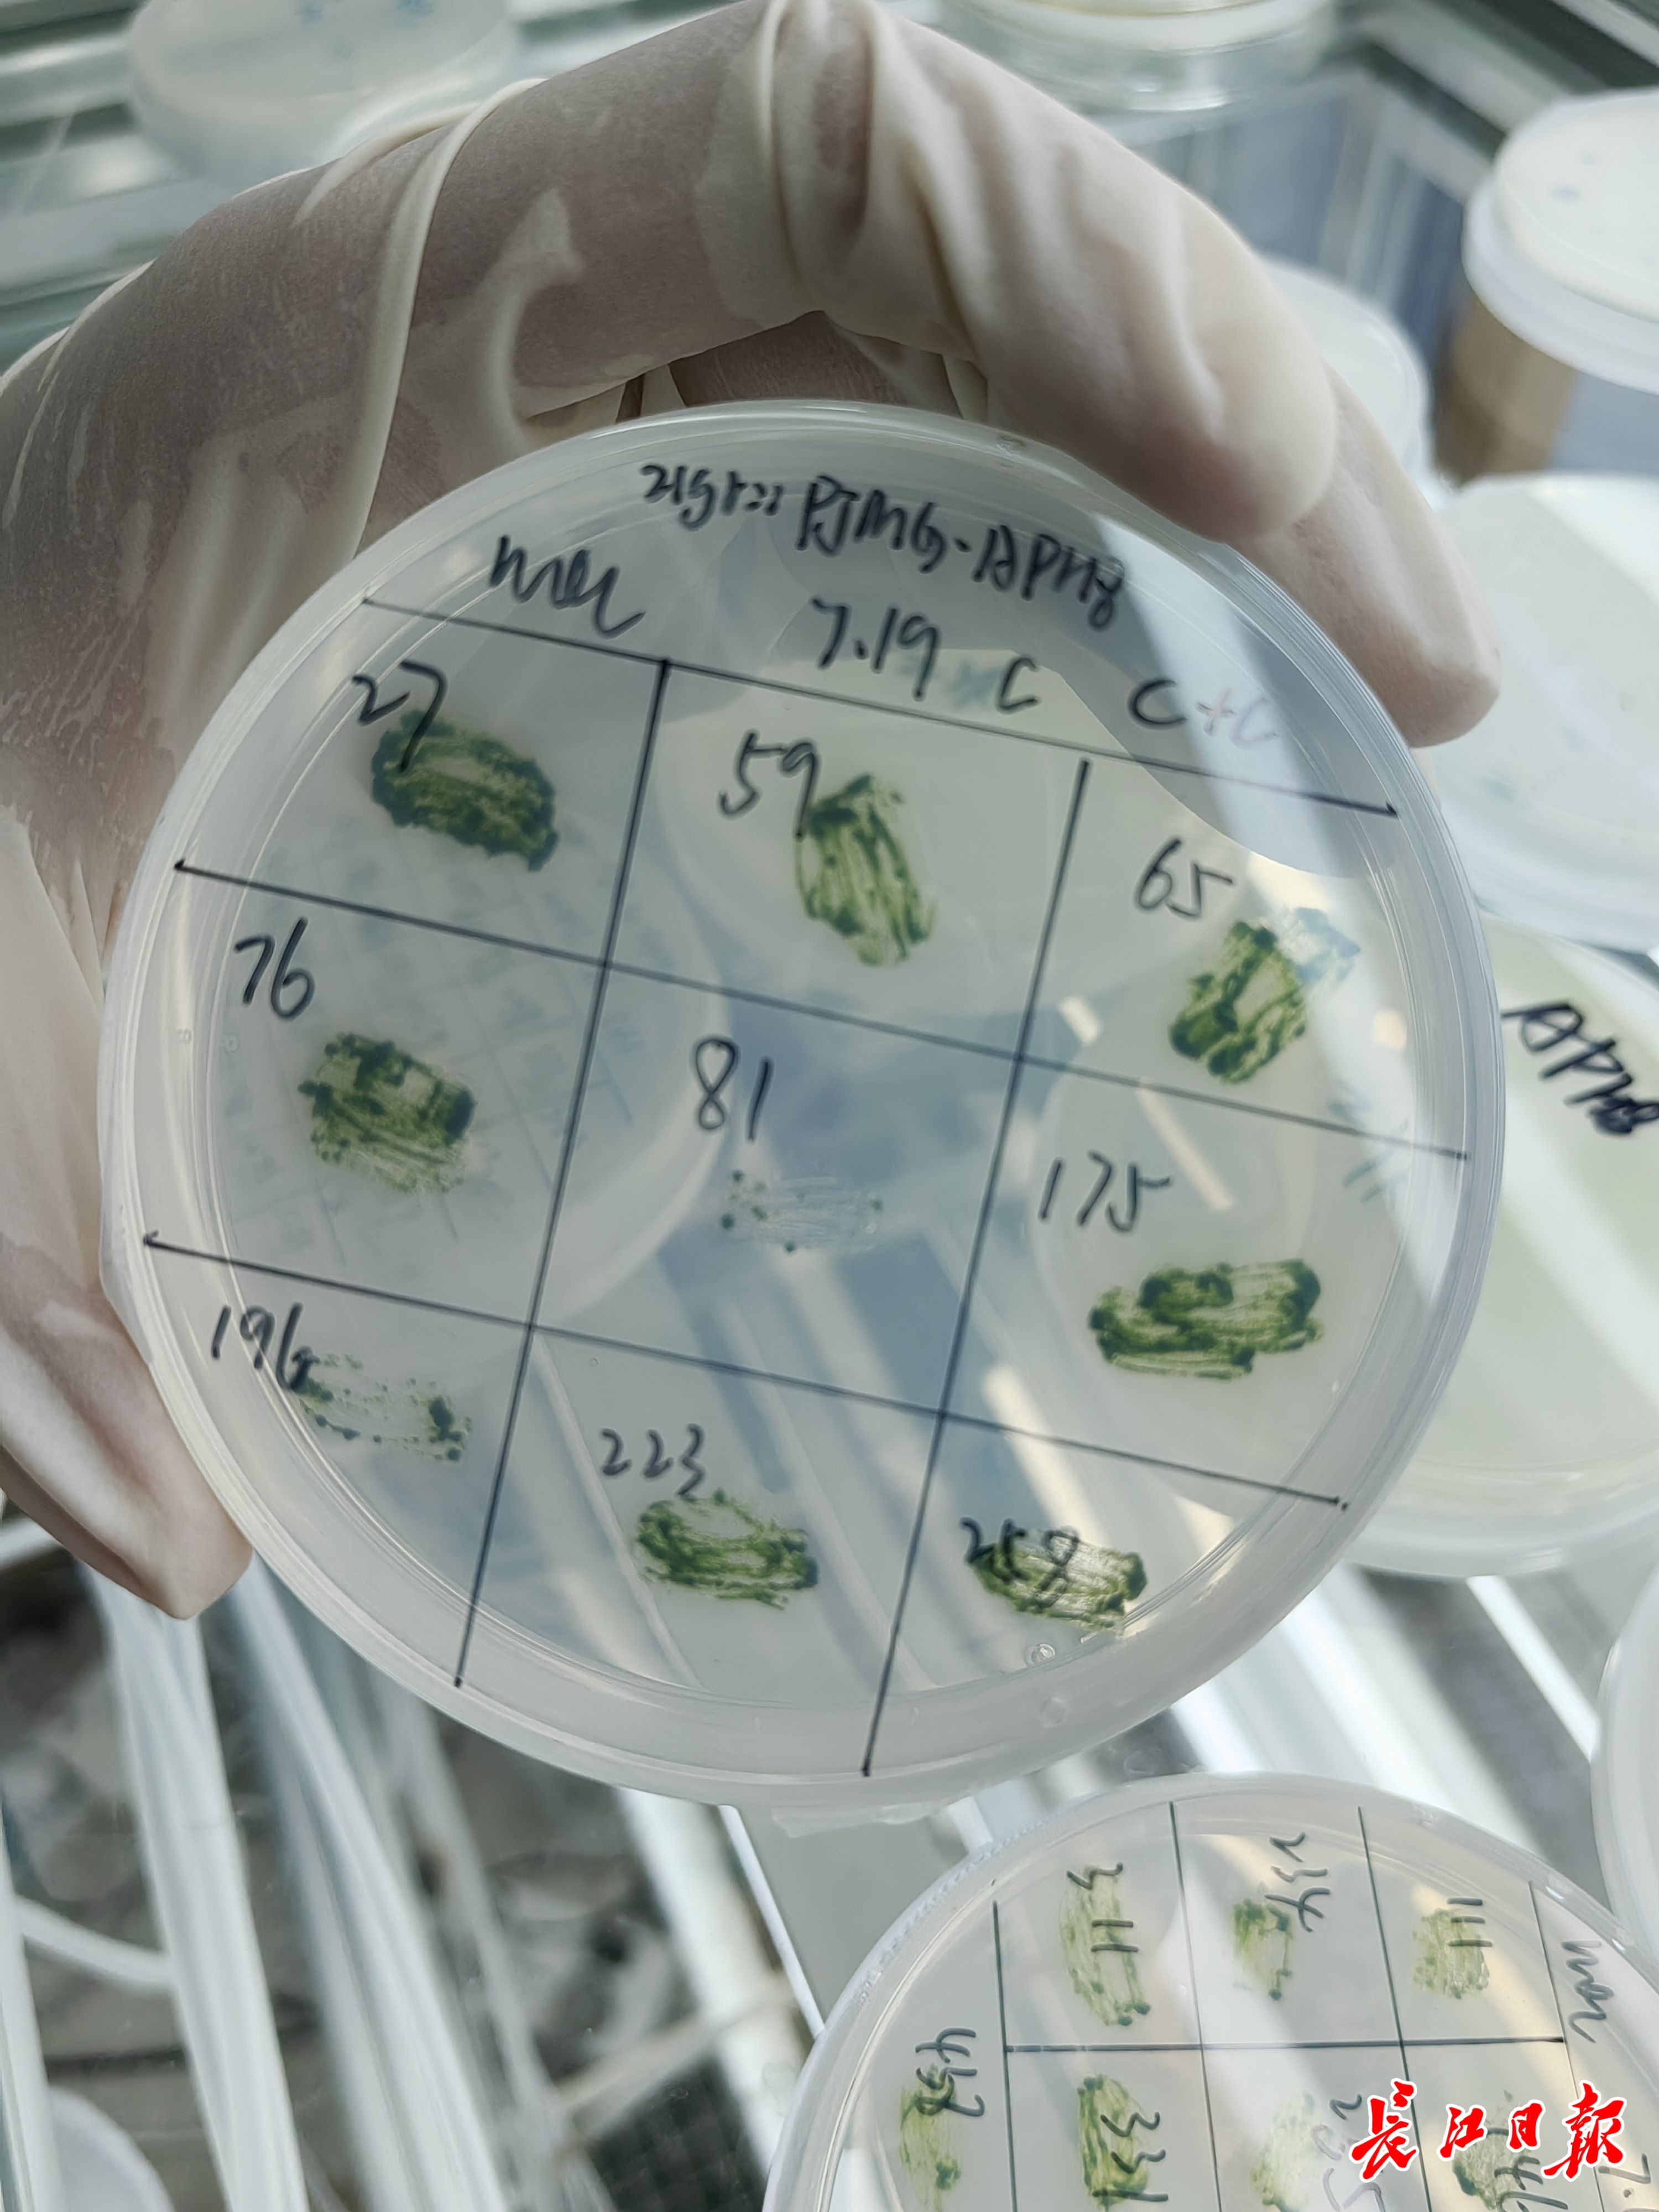

这几天,在沌口三角湖边的江汉大学校园里,36岁的胡长峰教授正忙着修改一篇关于微藻的论文,其成果事关一项新型靶向药物的研发。
微藻,一种直径5—10微米、比针尖还小的微小生物。15年前,胡长峰坐上“冷板凳”,开始研究微藻。
十多年时间,他带领团队研究出8000份具有自主知识产权的改良藻种。这些藻种在农业、医学等方面的应用转化,进入成果爆发期。
“微小世界也拥有广阔未来。”胡长峰确信,心无旁骛搞科研,这条路会越走越光明。

胡长峰教授正在开展微藻研究。记者金文兵 摄
找到科学界寻找近半个世纪的微藻“生物开关”
2006年,胡长峰考入吉林大学生物学专业,随后开始接触微藻。2010年本科毕业后,胡长峰“直博”入读清华大学生命科学学院,师承中国藻类研究专家潘俊敏。
2015年清华博士毕业后,胡长峰面临两个选择:要么去沿海地区跟着前辈搞研究,要么到武汉的江汉大学做自己喜欢的项目。立志做高质量研究的他,没有过多犹豫就落户武汉。他的研究方向十分明确——从微藻上寻找“治病良方”。

正在培育中的微藻。记者金文兵摄
胡长峰一头扎进实验室。他选择了微藻里的一种类似于“小白鼠”的单细胞生物——莱茵衣藻作为实验对象。
历经3年,千百次实验后,胡长峰带领团队在一株带有突变体的“变异”藻种中发现了一个全新的XAP5转录因子家族。这个转录因子相当于一个“生物开关”,可以调控藻体的一系列功能。胡长峰说,这个转录因子科研价值很高,微藻科学界为此寻找了近半个世纪。
而基于这个关键藻种,胡长峰团队申请到8项专利,跟进研究也收获了更多成果。“一株小小的微藻,通过自主光合作用,能不断增大自己的价值。”胡长峰认为科研工作者也应该坚守这样的“微藻人生”。
让微藻长出水蛭素治疗心脑血管疾病
微藻拥有完整细胞,兼具动物和植物特性,遗传操作体系完善,繁殖又快,在筛选重组蛋白药物时更为高效。继续深入研究,胡长峰团队发现XAP5因子能够“连接”单细胞生物与高等生物,可以通过对微藻进行“重组”的方式,开发出一系列“微藻药物”,应用于治疗人类疾病。这项研究获得国家自然科学基金、科技部重点研发计划等项目支持。
水蛭唾液中的水蛭素具有极强的抑制凝血和抗血栓形成作用,被誉为“血管清道夫”,应用于预防和治疗心脑血管疾病。因其获取不易、价格昂贵,又被称为“软黄金”。
那么,能不能尝试将水蛭素基因嫁接到莱茵衣藻上,让微藻生长出这种水蛭素呢?
江汉大学胡长峰团队成员正在观察微藻。记者金文兵 摄
去年,胡长峰团队在这一研究方向上实现突破。以莱茵衣藻为底盘,获得“重组水蛭素蛋白”,达到与天然水蛭素基本等同的效果。这种用于治疗心脑血管疾病的新型药物正在申报创新药。
今年4月,这项研究成果被江汉大学以职务科技成果赋权的方式,赋予胡长峰团队进行科技转化,赋权比例高达85%。随后,该成果以1200万元价格转让给北京耕天下生物科技有限公司,胡长峰团队由此获得千万元级别的成果转化奖励。
学生胡昆十分感谢老师的视野开阔,“他带领我在藻类世界里看到多彩的生活”。
近年来,胡长峰把微藻又引入生态治理、碳中和领域。胡长峰希望用微藻技术“滋养”湖北的绿水青山。今年10月,由胡长峰主持的国内首个微藻合成生物学与绿色制造研究院挂牌成立。
同事邢俊俏说,胡老师对研究工作充满激情,物质欲望极低。他不是在实验室,就是在家。
“我一个人的力量还远远不够。”胡长峰常常倡导开放合作的科研环境,鼓励学生跨学科交流,激发创新思维。在他的言传身教下,数十名学生走进各类高校和科研机构进一步深造。
(长江日报记者金文兵 通讯员李莎 高西)
【编辑:陈明】

请输入验证码